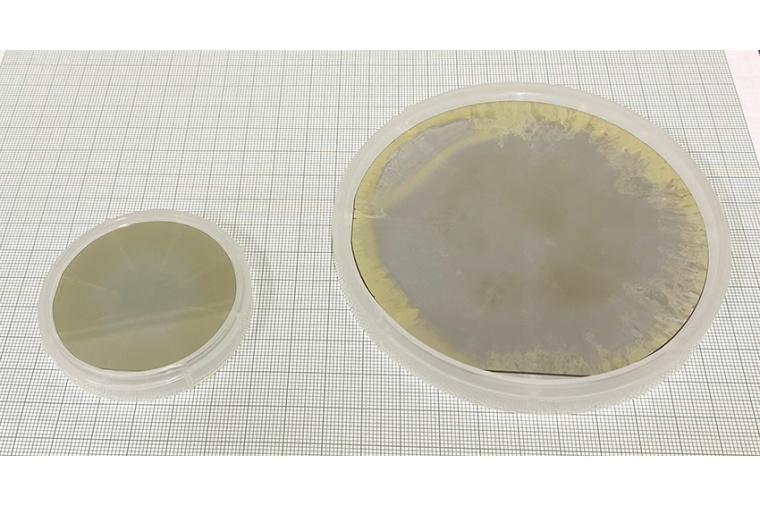

Crystal IS and Asahi Kasei produce first four-inch aluminum nitride substrate
This single-crystal aluminum nitride substrate demonstrates the scalability of Crystal IS processes for growing AlN bulk single-crystals.
Aluminum nitride substrates have low defect densities, high UV transparency, and low concentrations of impurities. AlN is attractive for a variety of industries, such as UVC LEDs and power devices, due to its ultra-wide bandgap and very high thermal conductivity. The four-inch substrate produced shows a usable area of over 80 percent based on current requirements for UVC LEDs.
Founded in 1997 to develop native aluminum nitride substrates, Crystal IS manufactures UVC LEDs on its commercial process for two-inch diameter substrates. These LEDs enable industry-leading reliability and performance at the ideal germicidal wavelengths from 260 nm – 270 nm. The current capacity of the facility can meet the volume requirements for consumer devices using UVC LEDs based on the existing two-inch production line.
Crystal IS currently produces thousands of two-inch substrates annually to support the production of its Klaran and Optan product lines.










